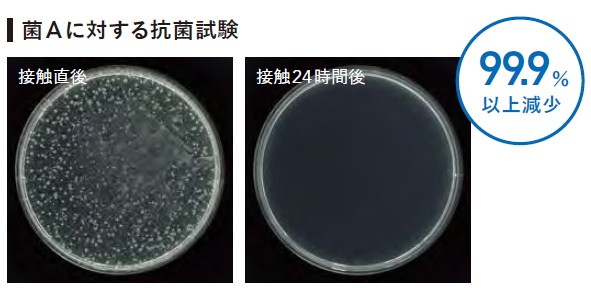
�R�ې�

初期メンテナンス
<床施工後の洗浄>
●床施工後は重量物の移動や仮り置きは避け、必ず養生等を行ってください。
●接着剤が十分に効果してから洗浄を行ってください。
●接着剤が硬化し、水洗いができるようになったら、水の使用はできるだけ抑えながら工事中の汚れを洗浄してください。
日常メンテナンス
<床面をいつもきれいに保つための予防清掃>
※マティルNW・ウッドラインNWシリーズは、ワックス塗布の必要はありませんが、ワックスメンテナンスも可能です。
定期メンテナンス
<日常のお手入れで落ちない汚れを洗浄>
●日常メンテナンスよりも濃い希釈濃度の洗浄液で洗浄してください。
●汚れが取り切れず、目立つ場合は、洗浄後にワックスを塗布し、ワックスメンテナンスに切り替えることも可能です。
補完メンテナンス
<定期的な洗浄でも取れない汚れを除去>
●固絞りの水拭きモップで汚れを拭き取ることをお勧めします。
●こびり付いた付着物は洗浄前に床がキズつかないようにヘラ等で、除去してください。
部分的な汚れは、専用洗浄液を使用し、赤のハンドバッド等で部分洗いしてください。